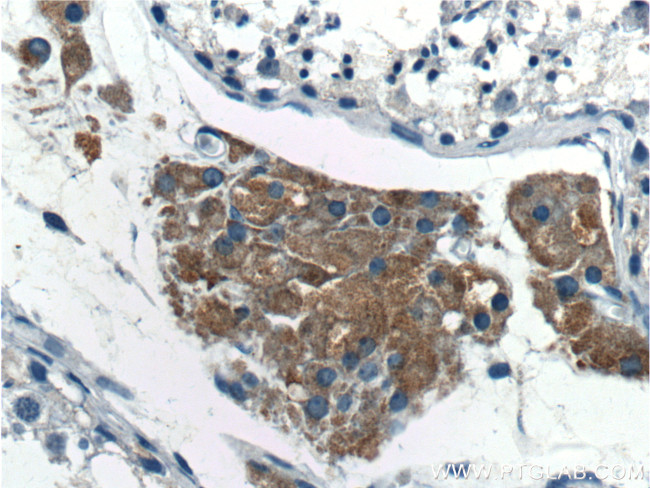
SPOCK2 Antibody in Immunohistochemistry (Paraffin) (IHC (P))

Search
Proteintech
SPOCK2 Polyclonal Antibody
{{$productOrderCtrl.translations['antibody.pdp.commerceCard.promotion.promotions']}}
{{$productOrderCtrl.translations['antibody.pdp.commerceCard.promotion.viewpromo']}}
{{$productOrderCtrl.translations['antibody.pdp.commerceCard.promotion.promocode']}}: {{promo.promoCode}} {{promo.promoTitle}} {{promo.promoDescription}}. {{$productOrderCtrl.translations['antibody.pdp.commerceCard.promotion.learnmore']}}
产品信息
11725-1-AP
种属反应
宿主/亚型
分类
类型
抗原
偶联物
形式
浓度
规格
纯化类型
保存液
内含物
保存条件
运输条件
产品详细信息
Immunogen sequence: ALAEGDAKG LKEGETPGNF MEDEQWLSSI SQYSGKIKHW NRFRDEVEDD YIKSWEDNQQ GDEALDTTKD PCQKVKCSRH KVCIAQGYQR AMCISRKKLE HRIKQPTVKL HGNKDSICKP CHMAQLASVC GSDGHTYSSV CKLEQQACLS SKQLAVRCEG PCPCPTEQAA TSTADGKPET CTGQDLADLG DRLRDWFQLL HENSKQNGSA SSVAGPASGL DKSLGASCKD SIGWMFSKLD TSADLFLDQT ELAAINLDKY EVCIRPFFNS CDTYKDGRVS TAEWCFCFWR EKPPCLAELE RIQIQEAAKK KPGIFIPSCD EDGYYRKMQC DQSSGDCWCV DQLGLELTGT RTHGSPDCDD IV (20-380 aa encoded by BC023558)
靶标信息
The SPOCK2 gene encodes the protein testican-2, a member of the SPARC (secreted protein acidic and rich in cysteine) family of extracellular matrix (ECM) proteins. SPOCK2 is involved in modulating the ECM environment, influencing cell-matrix interactions, tissue remodeling, and cellular communication. It plays a role in the regulation of proteolytic activity by inhibiting metalloproteinases, thereby contributing to the maintenance and integrity of the ECM. SPOCK2 is prominently expressed in the brain and testes, highlighting its involvement in neural development and reproductive biology. In neural tissues, it influences processes such as neuronal differentiation, synaptogenesis, and axonal guidance, which are critical for proper brain development and function. Dysregulation of SPOCK2 expression is associated with pathological conditions, including cancer, where it may impact tumor progression and metastasis through alterations in cell adhesion and migration. Research into SPOCK2's specific interactions and mechanisms continues, providing insights into its potential as a therapeutic target for managing ECM-related disorders and diseases involving abnormal cell-matrix interactions.
仅用于科研。不用于诊断过程。未经明确授权不得转售。
篇参考文献 (0)
生物信息学
蛋白别名: FLJ97039; KIAA0275; KIAA0275CWCV; SPARC/osteonectin, cwcv and kazal like domains proteoglycan 2; sparc/osteonectin, cwcv and kazal-like domains proteoglycan (testican) 2; SPARC/osteonectin, CWCV, and Kazal-like domains proteoglycan 2; Testican-2; unnamed protein product
基因别名: KIAA0275; SPOCK2; testican-2; TICN2; UNQ269/PRO306
UniProt ID: (Human) Q92563
Entrez Gene ID: (Human) 9806